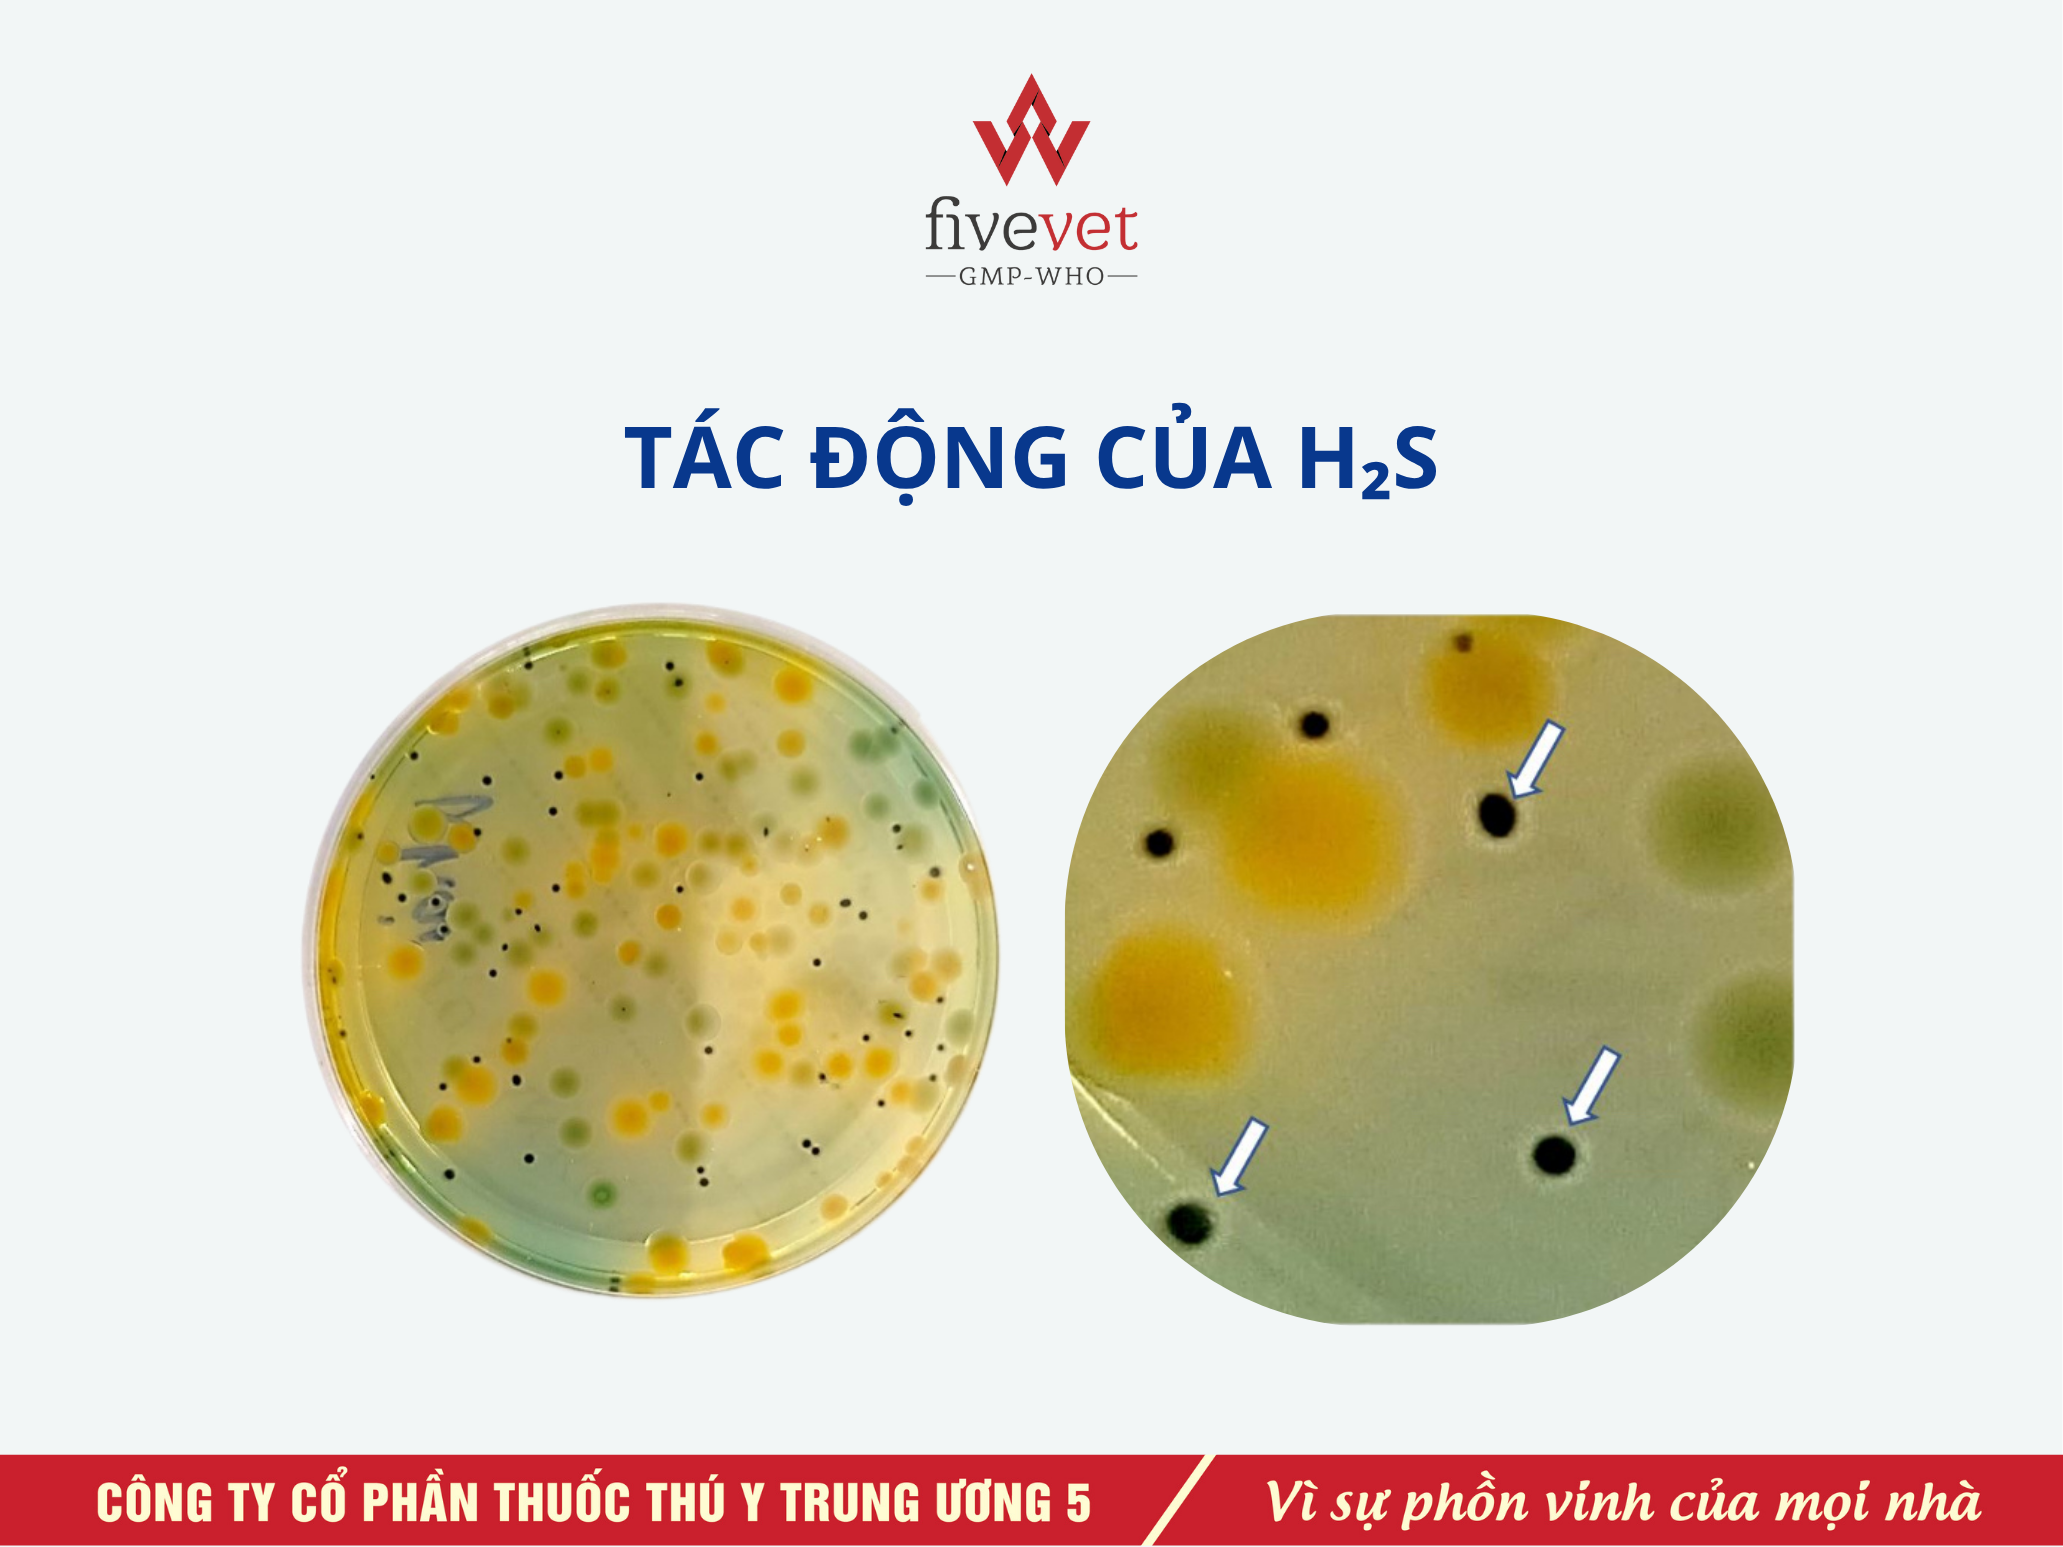

Khí độc trong ao là một trong những nguyên nhân có thể ảnh hưởng nghiêm trọng đến sức khỏe của tôm, đặc biệt là trong mô hình nuôi thâm canh, mật độ cao. Việc phát hiện sớm và xử lý kịp thời là chìa khóa để bảo vệ sức khỏe tôm và duy trì thành quả sau nhiều ngày chăm sóc. Thấu hiểu điều đó, FiveAqua (
Fivevet for Aqua) mang đến giải pháp toàn diện, từ nhận diện sớm, đến xử lý và phòng ngừa theo từng giai đoạn. Tất cả đều dựa trên các chế phẩm sinh học an toàn, giúp người nuôi chủ động kiểm soát khí độc một cách hiệu quả và bền vững.

Ao tôm bị khí độc: Cách phát hiện và giải pháp xử lý cấp cứu tôm
I. Khí độc trong ao tôm là gì? Tại sao lại nguy hiểm?
Trong quá trình nuôi tôm, môi trường nước đóng vai trò then chốt quyết định sự phát triển và sức khỏe của vật nuôi. Tuy nhiên nếu không được quản lý đúng cách, các hợp chất khí độc như NH₃ (ammonia), NO₂⁻ (nitrite) và H₂S (hydro sulfide) có thể tích tụ, gây ra những hậu quả nghiêm trọng.
Khí độc chủ yếu được sinh ra từ quá trình phân hủy yếm khí các chất hữu cơ như thức ăn thừa, phân tôm và xác tảo chết ở đáy ao. Khi nồng độ các khí này vượt ngưỡng an toàn, chúng sẽ tác động trực tiếp lên hệ hô hấp và tuần hoàn của tôm, làm giảm khả năng vận chuyển oxy trong máu, dẫn đến hiện tượng tôm nổi đầu, bơi lờ đờ, thậm chí chết hàng loạt.
Đây là một trong những vấn đề nghiêm trọng nhất mà người nuôi thường xuyên gặp phải. Nếu không được phát hiện sớm và xử lý đúng phương pháp, thiệt hại có thể lớn nhưng nếu can thiệp kịp thời có thể được kiểm soát hoàn toàn.
II. Dấu hiệu nhận biết ao tôm bị nhiễm khí độc
2.1. Biểu hiện trên con tôm
- Tôm nổi đầu, bơi dạt vào mé ao hoặc tập trung ở góc ao, đặc biệt là vào sáng sớm hoặc chiều tối khi lượng oxy hòa tan (DO) thấp.
- Tôm có dấu hiệu lột xác đồng loạt và liên tục, mềm vỏ, chậm cứng vỏ, chết đột ngột.
- Giảm ăn rõ rệt, đường ruột có thể trống rỗng hoặc màu sắc không ổn định.
- Tôm chuyển sang màu trắng đục, có dấu hiệu phồng mang, đen mang do tổn thương mang; thân tôm có thể ngả hồng.
- Tôm dễ bị stress và giảm sức đề kháng.
2.2. Biến đổi môi trường nước
- Nước có mùi trứng thối đặc trưng - dấu hiệu của H₂S.
- Màu nước thay đổi đột ngột: từ xanh đậm trở nên quá trong hoặc vẩn đục do tảo tàn và phân hủy.
- Đáy ao xuất hiện lớp bùn dày, nhớt, có mùi hôi khó chịu.
2.3. Kiểm tra bằng test kit
Việc sử dụng test kit đo NH₃/NH₄⁺, NO₂⁻, pH, DO là cần thiết để phát hiện khí độc ngay cả khi chưa có biểu hiện rõ ràng trên tôm. Điều này giúp người nuôi can thiệp nhanh chóng trước khi thiệt hại nghiêm trọng xảy ra.
III. Nguyên nhân hình thành khí độc trong ao nuôi
Khí độc sinh ra chủ yếu từ quá trình phân hủy yếm khí các chất hữu cơ như thức ăn thừa, phân tôm và xác tảo chết ở đáy ao. Khi không được quản lý tốt, lớp bùn hữu cơ dày tích tụ dưới đáy tạo điều kiện cho vi khuẩn kỵ khí hoạt động mạnh, sản sinh ra các khí độc như:
- NH₃: Gây tổn thương mang, làm giảm khả năng vận chuyển oxy trong máu tôm.
- NO₂⁻: Ức chế hô hấp, khiến tôm thiếu oxy và dễ sốc môi trường.
- H₂S: Khí không màu, có mùi trứng ung đặc trưng. Khi phản ứng với ion kim loại như Fe²⁺ trong nước, H₂S tạo ra kết tủa FeS màu đen ở đáy ao - đây cũng là nguyên nhân gây nhầm lẫn với “khí đen”. Loại khí này cực độc, chủ yếu gây hại đến mang và quá trình hô hấp của tôm. Ở nồng độ cao, có thể ảnh hưởng đến hoạt động thần kinh và chuyển hóa khiến tôm mất phản xạ, chết đột ngột.
Ngoài ra, ảnh hưởng của pH cũng là yếu tố quan trọng. Khi pH > 8.3, tỷ lệ NH₃ (dạng độc) tăng cao, gây nguy hiểm lớn cho tôm.
Hình minh họa tác động của H₂S
Tôm nuôi tiếp xúc bùn đen
IV. Quy trình xử lý khẩn cấp khi tôm bị ngộ độc khí
Khi phát hiện tôm có dấu hiệu ngộ độc khí, cần hành động nhanh chóng theo quy trình sau:
Bước 1: Tăng cường oxy hòa tan
- Bật toàn bộ hệ thống quạt nước và máy sục khí ở công suất tối đa để tăng nồng độ DO trong nước.
- Nếu có thể, sử dụng Oxy dạng viên với liều lượng 1-2 kg/1.000 m3 hoặc lắp đặt thêm các thiết bị tạo oxy đáy ao.

Quạt sục khí mạnh trong ao nuôi
Bước 2: Ngừng cho ăn
- Dừng cho ăn ít nhất 1 ngày để giảm áp lực chuyển hóa trong môi trường nước và hạn chế nguồn phát sinh khí độc mới.
Bước 3: Giảm nhanh nồng độ khí độc
- Sử dụng chất hấp thu khí độc dạng Yucca (ví dụ:
Five-Yucca Bio Super) giúp giảm nồng độ khí độc như NH₃, NO2 H₂S nhờ cơ chế liên kết và kết tủa sinh học, hỗ trợ cải thiện chất lượng nước.
- Pha loãng và tạt đều khắp mặt ao theo hướng dẫn của nhà sản xuất.
Bước 4: Hỗ trợ phục hồi sức khỏe tôm
- Bổ sung vitamin C và vitamin nhóm B (ví dụ:
Five-Stress C,
B.Comlex KC TS) giúp tăng cường sức đề kháng, giảm stress.
- Có thể kết hợp sử dụng khoáng chất để tôm phát triển khỏe mạnh, giúp tôm lột xác dễ dàng.

Sản phẩm hỗ trợ phục hồi sức khỏe tôm
Bước 5: Cải thiện môi trường nước
- Thay khoảng 40-60% nước ao bằng nguồn nước sạch đã qua xử lý.
- Sử dụng chế phẩm vi sinh giúp phân hủy chất hữu cơ, ổn định môi trường nước và đáy ao.
- Dùng sát trùng nước an toàn (như
Five-Virpond,
Hado-PVP Iodine) để tiêu diệt nhanh chóng các loại vi khuẩn gây bệnh cho tôm.
V. Giải pháp phòng ngừa và xử lý triệt để khí độc
5.1. Sử dụng men vi sinh định kỳ
Vi sinh là giải pháp sinh học lâu dài, giúp giảm thiểu nguyên nhân hình thành khí độc khi được sử dụng định kỳ đúng cách. Tùy vào mục đích sử dụng, người nuôi có thể lựa chọn loại vi sinh thích hợp nhằm tối ưu hiệu quả.
- Xử lý đáy ao: Sử dụng
Five-Bazym chứa các chủng vi sinh dạng bào tử, chuyên phân hủy nhanh bã hữu cơ, giảm mùn đáy và loại bỏ các khí độc trong ao nuôi.
- Làm sạch nước và xử lý nhớt bạt: Với ao lót bạt, dùng
Five-Biozym Super để loại bỏ nhớt, rong nhớt và duy trì độ trong của nước.

Một số sản phẩm phòng ngừa và xử lý khí độc
5.2. Bổ sung dinh dưỡng và khoáng chất
- Bảo vệ gan tụy: Dùng
Five-Diệp Hạ Châu giúp tăng cường chức năng gan, hỗ trợ tôm giải độc hiệu quả hơn.
- Bổ sung các nhóm vitamin và acid amin cần thiết: Dùng
Five-Aminovit Super TS giúp tăng cường hệ miễn dịch và tăng trọng nhanh.
- Bổ sung khoáng chất: Sử dụng
Five-Superal để cung cấp khoáng, giúp lột xác đồng đều và tăng cường vỏ cứng.
5.3. Quản lý môi trường nước định kỳ
- Đo đạc và theo dõi các thông số môi trường (pH, DO, NH₃, NO₂⁻) ít nhất 3-5 lần/tuần.
- Thay nước định kỳ hằng ngày từ 20-30% nước để làm sạch nước, giảm tảo, giảm nồng độ khí độc.
- Thực hiện xi-phông đáy ao thường xuyên nhằm loại bỏ cặn bã hữu cơ.
- Kiểm soát mật độ tảo, tránh hiện tượng tảo tàn gây ô nhiễm nước.
Khí độc trong ao nuôi tôm cũng là mối đe dọa tiềm ẩn tuy nhiên rất dễ kiểm soát nếu người nuôi theo dõi môi trường nước thường xuyên và có biện pháp xử lý phù hợp. Việc áp dụng đúng quy trình kỹ thuật, kết hợp giữa theo dõi định kỳ, sử dụng chế phẩm sinh học và can thiệp cấp cứu hợp lý, sẽ giúp người nuôi đảm bảo môi trường sống ổn định, tăng khả năng sinh trưởng và giảm thiểu rủi ro trong quá trình nuôi. Hy vọng bài viết này cung cấp đầy đủ kiến thức kỹ thuật giúp người nuôi tôm chủ động trong công tác quản lý môi trường và chăm sóc thủy sản, hướng tới mô hình nuôi bền vững và hiệu quả.
Câu hỏi thường gặp
1. Khi nào cần kiểm tra khí độc trong ao tôm?
- Định kỳ 3-5 ngày/lần đối với mô hình thâm canh.
- Kiểm tra ngay sau mưa lớn, nắng nóng kéo dài, tảo tàn hoặc khi thấy tôm ăn yếu.
2. Ngưỡng an toàn của khí độc trong ao tôm
- Đối với khí Amoniac (NH₃): Nồng độ an toàn là phải dưới 0.1 mg/L. Vượt qua mức này là bắt đầu nguy hiểm tới sức khỏe của tôm.
- Đối với khí Nitrit (NO₂): Cần duy trì ở mức dưới 1.0 mg/L. Nếu chỉ số này cao hơn 1.0 mg/L, tôm sẽ có nguy cơ mắc bệnh máu nâu, ngạt thở và chết.
- Đối với khí Hydro Sunfua (H₂S): Đây là loại khí cực độc, ngưỡng an toàn của H₂S là càng gần 0 càng tốt và nên < 0.01 mg/L để tránh gây ảnh hưởng đến hệ hô hấp và thần kinh của tôm.
3. Cách xử lý từng loại khí độc
- NH₃ và NO₂⁻: Dùng vi sinh phân hủy protein và nitơ hữu cơ, thay nước, dùng Yuca để hấp thu khí độc.
- H₂S: Kết hợp xi-phông đáy ao thường xuyên và dùng vi sinh xử lý lưu huỳnh.
4. Men vi sinh có thể khử khí độc ngay lập tức không?
Không. Men vi sinh cần thời gian để phát triển và phân giải các chất hữu cơ, do đó chỉ phù hợp cho việc phòng ngừa lâu dài. Trong trường hợp cấp cứu, cần dùng chất hấp thụ khí độc dạng Yucca.
5. Cách xử lý cấp cứu khi tôm nổi đầu do khí độc?
Tăng cường sục khí, ngưng cho ăn, tạt Yucca (như
Five-Yucca Bio Super) để hấp thu khí độc. Sau đó bổ sung vitamin B, C (
B.Comlex KC TS,
Five-Stress C) giúp tôm giảm stress, phục hồi nhanh chóng. Kết hợp thay nước và dùng vi sinh như
Five-Bazym để cải thiện chất lượng nước, giảm khí độc trong ao nuôi.
Xem thêm:
-
Men vi sinh trong thủy sản: Giải pháp xanh cho môi trường ao nuôi
-
6 cách tăng pH ao nuôi tôm - Kỹ thuật nuôi tôm đỉnh cao
-
Bệnh hoại tử cơ trên tôm - Dấu hiệu nhận biết và cách phòng tránh kịp thời